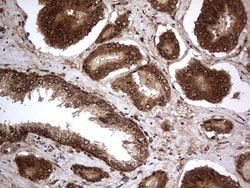
H2AFY2 Monoclonal Antibody (OTI1C2), TrueMAB , OriGene 100 &mu;L; Unconjugated:Antibodies,

Learn More
H2AFY2 Monoclonal Antibody (OTI1C2), TrueMAB™, OriGene
Mouse Monoclonal Antibody
Brand: Origene Technologies TA803386

Description
Variant histone H2A which replaces conventional H2A in a subset of nucleosomes where it represses transcription. Nucleosomes wrap and compact DNA into chromatin, limiting DNA accessibility to the cellular machineries which require DNA as a template. Histones thereby play a central role in transcription regulation, DNA repair, DNA replication and chromosomal stability. DNA accessibility is regulated via a complex set of post-translational modifications of histones, also called histone code, and nucleosome remodeling. May be involved in stable X chromosome inactivation.Specifications
| H2AFY2 | |
| Monoclonal | |
| 1 mg/mL | |
| PBS with 1% BSA, 50% glycerol and 0.02% sodium azide | |
| Q9P0M6 | |
| H2AFY2 | |
| Human recombit protein fragment corresponding to amino acids 2-261 of human H2AFY2 produced in E.coli. | |
| 100 μL | |
| Primary | |
| Human | |
| Antibody | |
| IgG2a |
| Immunohistochemistry (Paraffin), Western Blot | |
| OTI1C2 | |
| Unconjugated | |
| H2AFY2 | |
| macroH2A2 | |
| Mouse | |
| Affinity Chromatography | |
| RUO | |
| 55506 | |
| -20° C, Avoid Freeze/Thaw Cycles | |
| Liquid |
The Fisher Scientific Encompass Program offers items which are not part of our distribution portfolio. These products typically do not have pictures or detailed descriptions. However, we are committed to improving your shopping experience. Please use the form below to provide feedback related to the content on this product.